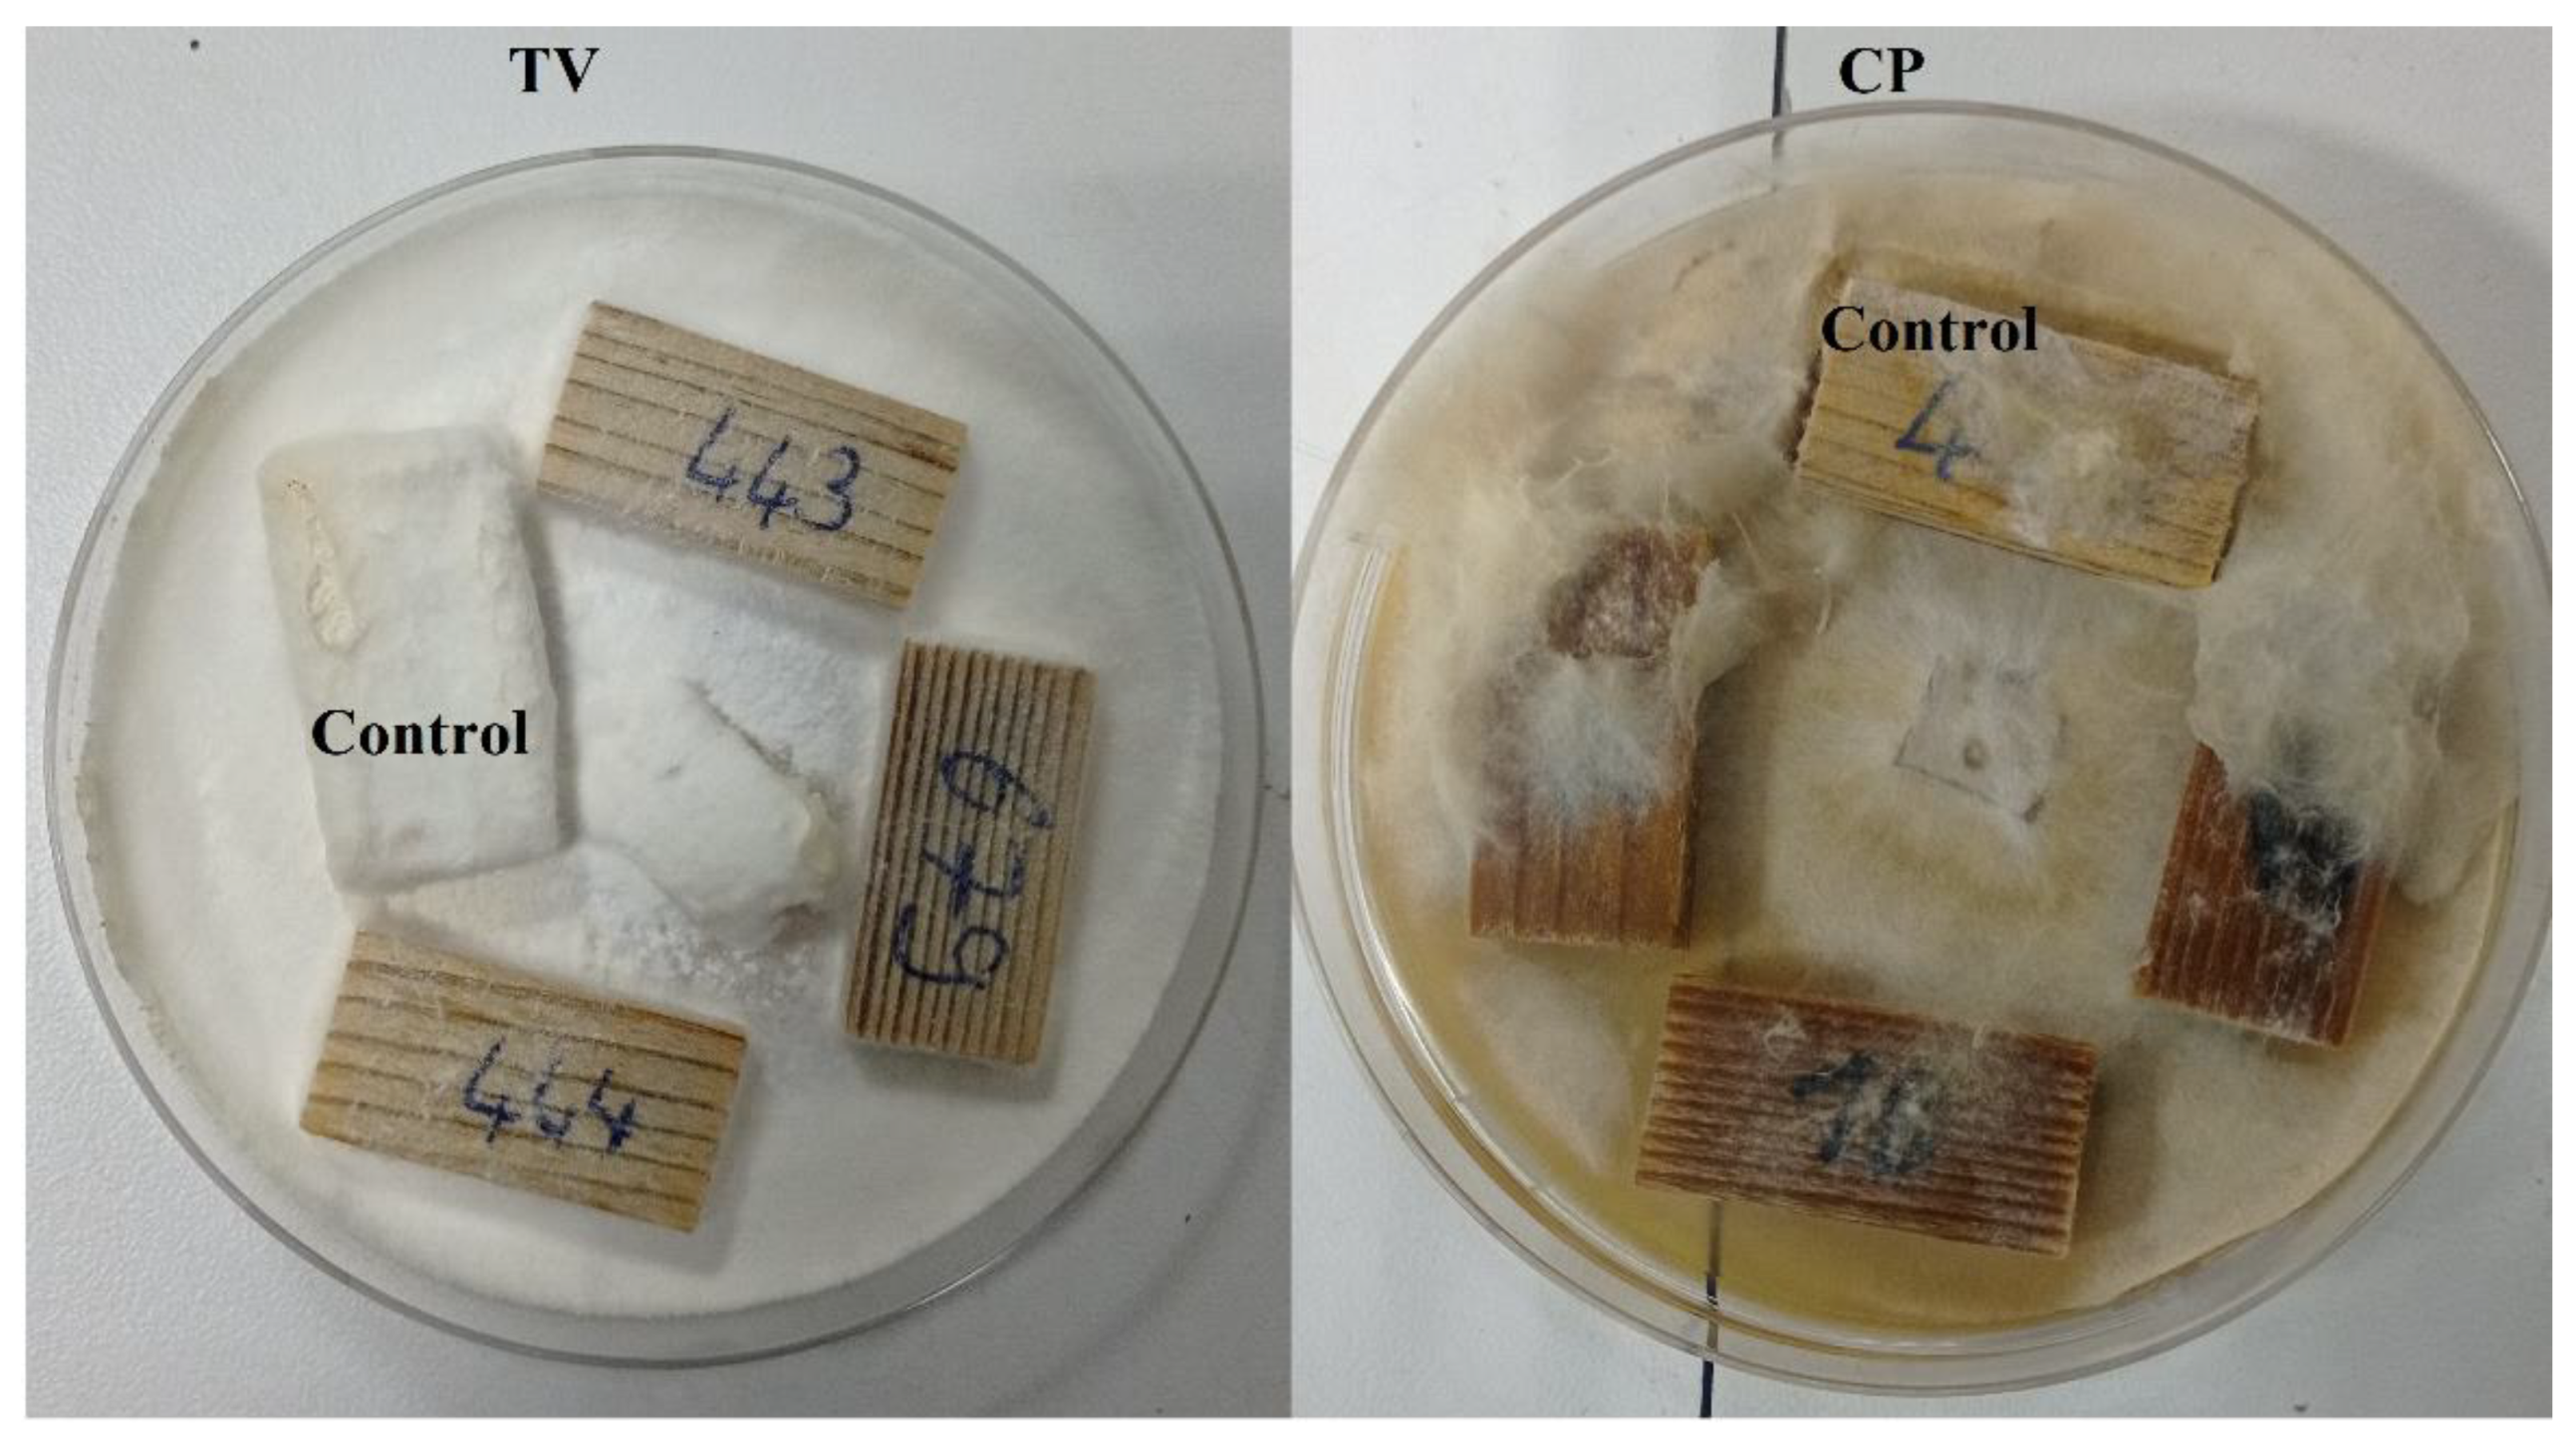
Forests 13 02137 g007 Forests 13 02137 g007

n-Heptadecane-Impregnated Wood as a Potential Material for Energy-Saving Buildings
Abstract
1. Introduction
2. Materials and Methods
2.1. Materials
2.2. Impregnation of Wood Samples with PCM (PCMW)
2.3. Decay Test
2.4. Characterization of PCM and PCMW
3. Results and Discussion
4. Conclusions
Author Contributions
Funding
Data Availability Statement
Acknowledgments
Conflicts of Interest
References
- Zhou, D.; Zhao, C.Y.; Tian, Y. Review on thermal energy storage with phase change materials (PCMs) in building applications. Apply Energy 2012, 92, 593–605. [Google Scholar] [CrossRef]
- Palacio, S.N.; Valentine, K.F.; Wong, M. Reducing power system costs with thermal energy storage. Appl. Energy 2014, 129, 228–237. [Google Scholar] [CrossRef]
- Sharma, R.K.; Ganesan, P.; Tyagi, V.V.; Metselaar, H.S.C.; Sandaran, S.C. Developments in organic solid–liquid phase change materials and their applications in thermal energy storage. Energy Convers. Manag. 2015, 95, 193–228. [Google Scholar] [CrossRef]
- Yu, S.; Wang, X.; Wu, D. Microencapsulation of n-octadecane phase change material with calcium carbonate shell for enhancement of thermal conductivity and serving durability: Synthesis, microstructure, and performance evaluation. Appl. Energy 2014, 114, 632–643. [Google Scholar] [CrossRef]
- Fu, X.; Kong, W.; Zhang, Y.; Jiang, L.; Wang, J.; Lei, J. Novel solid–solid phase change materials with biodegradable trihydroxy surfactants for thermal energy storage. RSC Adv. 2015, 5, 68881–68889. [Google Scholar] [CrossRef]
- Sundararajan, S.; Samui, A.B.; Kulkarni, P.S. Versatility of polyethylene glycol (PEG) in designing solid-solid phase change materials (PCMs) for thermal management and their application to innovative Technologies. J. Mater. Chem. A 2017, 5, 18379–18396. [Google Scholar] [CrossRef]
- Liu, J.; Jia, S.; Lin, X.; Cao, H.; Wang, W.; Guo, X.; Sun, W. Fabrication of thermal energy storage wood composite based on shape-stable phase change material. Mater. Res. Express 2021, 8, 055304. [Google Scholar] [CrossRef]
- Feczkó, T.; Kardos, A.F.; Németh, B.; Trif, L.; Gyenis, J. Microencapsulation of n-hexadecane phase change material by ethyl cellulose polymer. Polym. Bull. 2014, 71, 3289–3304. [Google Scholar] [CrossRef]
- Irani, F.; Ranjbar, Z.; Moradian, S.; Jannesari, A. Microencapsulation of n-heptadecane phase change material with starch shell. Prog. Org. Coat. 2017, 113, 31–38. [Google Scholar] [CrossRef]
- Behzadi, S.; Farid, M.M. Experimental and numerical investigations on the effect of using phase change materials for energy conservation in residential buildings. HVACR Res. 2011, 17, 366–376. [Google Scholar] [CrossRef]
- Kousksou, T.; Bruel, P.; Jamil, A.; El Rhafiki, T.; Zeraouli, Y. Energy storage: Applications and challenges. Sol. Energy Mater. Sol. Cells Part A 2014, 120, 59–80. [Google Scholar] [CrossRef]
- Shahbaz, K.; AlNashef, I.M.; Lin, R.J.T.; Hashim, M.A.; Mjalli, F.S.; Farid, M.M. A novel calcium chloride hexahydrate-based deep eutectic solvent as a phase change materials. Sol. Energy Mater. Sol. Cells 2016, 155, 147–154. [Google Scholar] [CrossRef]
- Mathis, D.; Blanchet, P.; Landry, V.; Lagière, P. Impregnation of wood with microencapsulated bio-based phase change materials for high thermal mass engineered wood flooring. Appl. Sci. 2018, 8, 2696. [Google Scholar] [CrossRef]
- Sarı, A.; Saleh, T.A.; Hekimoğlu, G.; Tyagi, V.V.; Sharma, R.K. Microencapsulated heptadecane with calcium carbonate as thermal conductivity-enhanced phase change material for thermal energy storage. J. Mol. Liq. 2021, 328, 115508. [Google Scholar] [CrossRef]
- Li, J.; Xue, P.; Ding, W.; Han, J.; Sun, G. Micro-encapsulated paraffin/high-density polyethylene/wood flour composite as form-stable phase change material for thermal energy storage. Sol. Energy Mater. Sol. Cell 2009, 93, 1761–1767. [Google Scholar] [CrossRef]
- Ma, L.; Wang, Q.; Li, L. Delignified wood/capric acidpalmitic acid mixture stable-form phase change material for thermal storage. Sol. Energy Mater. Sol. Cell 2019, 194, 215–221. [Google Scholar] [CrossRef]
- Wang, T.Y.; Wang, S.F.; Luo, R.L.; Zhu, C.Y.; Akiyama, T.; Zhang, Z.G. Microencapsulation of phase change materials with binary cores and calcium carbonate shell for thermal energy storage. Appl Energy 2016, 171, 113–119. [Google Scholar] [CrossRef]
- Konuklu, Y.; Unal, M.; Paksoy, H.O. Microencapsulation of caprylic acid with different wall materials as phase change material for thermal energy storage. Sol. Energy Mater. Sol. Cells 2014, 120, 536–542. [Google Scholar] [CrossRef]
- Jacob, R.; Bruno, F. Review on shell materials used in the encapsulation of phase change materials for high temperature thermal energy storage. Renew. Sustain. Energy Rev. 2015, 48, 79–87. [Google Scholar] [CrossRef]
- Liang, K.; Shi, L.; Zhang, J.; Cheng, J.; Wang, X. Fabrication of shape-stable composite phase change materials based on lauric acid and graphene/graphene oxide complex aerogels for enhancement of thermal energy storage and electrical conduction. Thermochim. Acta 2018, 664, 1–15. [Google Scholar] [CrossRef]
- Jeong, S.G.; Jeon, J.; Lee, J.H.; Kim, S. Optimal preparation of PCM/diatomite composites for enhancing thermal properties. Int. J. Heat Mass Transf. 2013, 62, 711–717. [Google Scholar] [CrossRef]
- Wen, R.; Huang, Z.; Huang, Y.; Zhang, X.; Min, X.; Fang, M.; Liu, Y.; Wu, X. Synthesis and characterization of lauric acid/expanded vermiculite as form-stabilized thermal energy storage materials. Energy Build. 2016, 116, 677–683. [Google Scholar] [CrossRef]
- Zhang, H.; Zhang, L.; Li, Q.; Huang, C.; Guo, H.; Xiong, L.; Chen, X. Preparation and characterization of methyl palmitate/palygorskite composite phase change material for thermal energy storage in buildings. Construct. Build. Mater. 2019, 226, 212–219. [Google Scholar] [CrossRef]
- Hekimoğlu, G.; Sarı, A.; Kar, T.; Keleş, S.; Kaygusuz, K.; Yıldırım, N.; Tyagi, V.V.; Sharma, R.K.; Saleh, T.A. Carbonized waste hazelnut wood-based shape-stable composite phase change materials for thermal management implementations. Int. J. Energy Res. 2021, 45, 10271–10284. [Google Scholar] [CrossRef]
- Amini, M.H.M.; Temiz, A.; Hekimoğlu, G.; Demirel, G.K.; Sarı, A. Properties of Scots pine wood impregnated with capric acid for potential energy saving building material. Holzforschung 2022, 76, 744–753. [Google Scholar] [CrossRef]
- Green, D.W.; Winandy, J.E.; Kretschmann, D.E. Mechanical properties of wood. In Wood Handbook, Wood as an Engineering Material; USDA Forest Service, Forest Products Laboratory: Madison, WI, USA, 1999; pp. 4.1–4.45. [Google Scholar]
- Fengel, D.; Wegener, G. Wood: Chemistry, Ultrastructure, Reactions; Walter de Gruyter and Co.: Berlin, Germany, 1983; ISBN 3-11-008481-3. [Google Scholar]
- Asif, M. Sustainability of Timber, Wood and Bamboo in Construction. In Sustainability of Construction Materials; Elsevier: Amsterdam, The Netherlands, 2009; pp. 31–54. [Google Scholar]
- Hill, C.A.S. Wood Modification: Chemical, Thermal and Other Processes; John Wiley & Sons, Ltd.: Chichester, UK, 2006. [Google Scholar]
- Rowell, R. Chemical modification of wood to produce stable and durable composites. Cellul. Chem. Technol. 2012, 46, 443–448. [Google Scholar]
- Jiang, J.; Zhou, Y.; Mei, C.; Cao, J. Polyethylene glycol and silica sol penetration improves hydrophobicity and dimensional stability of wood after a short-time treatment. Eur. J. Wood Wood Prod. 2021, 79, 1395–1404. [Google Scholar] [CrossRef]
- Bravery, A.F. A miniaturised wood-block test for the rapid evaluation of wood preservative fungicides. In Screening techniques for potential wood preservative chemicals. Proceedings of a special seminar held in association with the 10th annual meeting of the IRG/WP 1979; pp. 57–65.
- Torun, S.B.; Tomak, E.D.; Cavdar, A.D.; Mengeloglu, F. Characterization of weathered MCC/nutshell reinforced composites. Polym. Test. 2021, 101, 107290. [Google Scholar] [CrossRef]
- Ermeydan, M.A.; Cambazoğlu, M.; Tomak, E.D. A methodological approach to ε-caprolactone modification of wood. J. Wood Chem. Technol. 2022, 42, 1–11. [Google Scholar] [CrossRef]
- El Hachem, C.; Abahri, K.; Leclerc, S.; Bennacer, R. NMR and XRD quantification of bound and free water interaction of spruce wood fibers. Constr. Build. Mater. 2020, 260, 120470. [Google Scholar] [CrossRef]
- EN 113-2; Durability of wood and wood-based products—Test method against wood destroying basidiomycetes—Part 2: Assessment of inherent or enhanced durability. European Committee for Standardization: Brussels, Belgium, 2020.
- Lesar, B.; Humar, M. Use of wax emulsion for improvement of wood durability and sorption properties. Eur. J. Wood Wood Prod. 2011, 69, 231–238. [Google Scholar] [CrossRef]
- Archer, K.; Leebow, S. Primary Wood Processing: Principles and Practice. In Wood Preservation; Walker, J.C.F., Ed.; Springer: Dordrecht, The Netherlands, 2006; Chapter 9; pp. 297–338. [Google Scholar]
- Reinprecht, L.; Repák, M. The impact of paraffin-thermal modification of beech wood on its biological, physical and mechanical properties. Forests 2019, 10, 1102. [Google Scholar] [CrossRef]

Publisher’s Note: MDPI stays neutral with regard to jurisdictional claims in published maps and institutional affiliations. |
© 2022 by the authors. Licensee MDPI, Basel, Switzerland. This article is an open access article distributed under the terms and conditions of the Creative Commons Attribution (CC BY) license (https://creativecommons.org/licenses/by/4.0/).
Share and Cite
Can, A.; Žigon, J. n-Heptadecane-Impregnated Wood as a Potential Material for Energy-Saving Buildings. Forests 2022, 13, 2137. https://doi.org/10.3390/f13122137
Can A, Žigon J. n-Heptadecane-Impregnated Wood as a Potential Material for Energy-Saving Buildings. Forests. 2022; 13(12):2137. https://doi.org/10.3390/f13122137
Chicago/Turabian StyleCan, Ahmet, and Jure Žigon. 2022. "n-Heptadecane-Impregnated Wood as a Potential Material for Energy-Saving Buildings" Forests 13, no. 12: 2137. https://doi.org/10.3390/f13122137
APA StyleCan, A., & Žigon, J. (2022). n-Heptadecane-Impregnated Wood as a Potential Material for Energy-Saving Buildings. Forests, 13(12), 2137. https://doi.org/10.3390/f13122137







